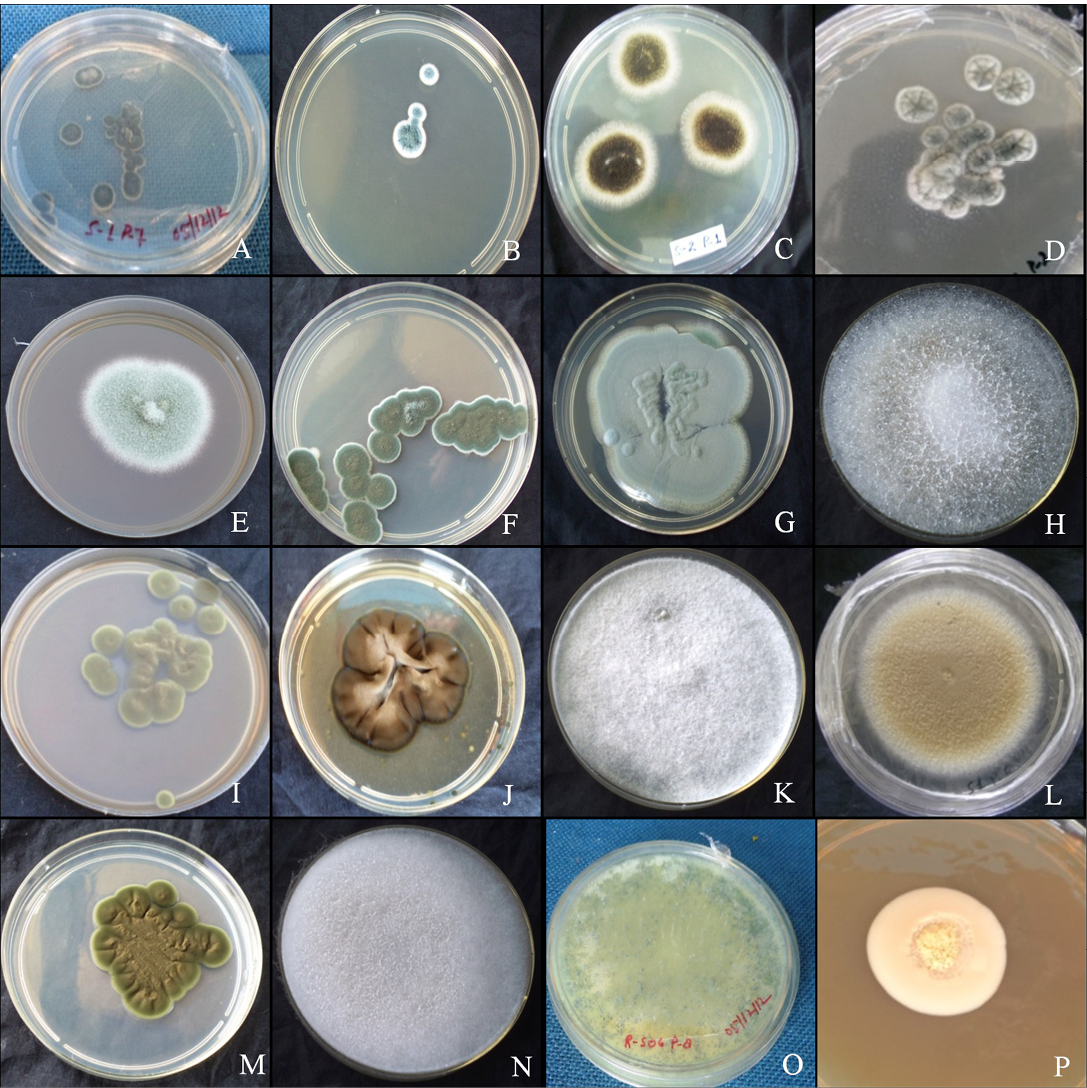

South Asian Journal of Life Sciences
Colony morphology A. versicolar gr (A), A. flavus (B) and A. niger (C). Aspergillus sp. (D), Penicillium funiculosum (E), Penicillium sp. (F), Penicillium sp. (G), Absidia corymbifera (H), Cladosporium cladosporiodes (I), Cladosporium resinae (J), Chrysosporium tropicum (K), Paecilomyces varitii (L), Malbranchea sp. (M), Mucor sp. (N), Trichoderma sp. (O) and yeast sp. (P)
Scanning electron micrographs of A. versicolar gr (A), A. flavus (B) and A. niger (C). Aspergillus sp. (D), Penicillium funiculosum (E), Penicillium sp. (F), Penicillium sp. (G), Absidia corymbifera (H), Cladosporium cladosporiodes (I), Cladosporium resinae (J), Chrysosporium tropicum (K), Paecilomyces varitii (L), Malbranchea sp. (M), Mucor sp. (N), Trichoderma sp. (O) and yeast sp. (P)